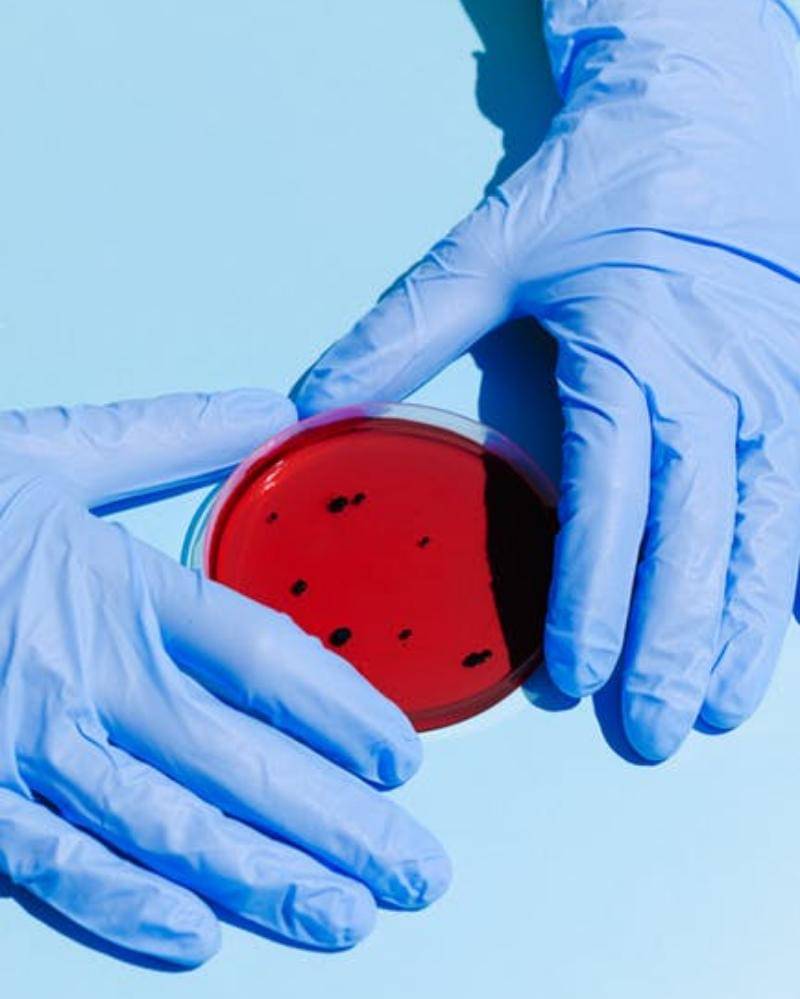
Pexel/Anna Shvets

Presiden Jokowi Prediksi Virus Corona Bertahan Hingga Akhir Tahun 2020

Selasa (21/4), sudah mencapai 7.000-an yang dinyatakan positif virus corona, harus sampai berapa lagi penyakit ini memburu manusia Republik ini?
Setidaknya dampak besar sudah diberikan pada kehidupan kita. Ekonomi sosial dan budaya sudah merasakan perbedaannya.
Perlu adanya peran serta semua lapisan masyarakat dalam menghadapi perang 'survival' ini. Kita yang bertahan atau virus yang bertahan.
Saking besarnya dampak virus corona ini hingga menuai komentar dari banyak tokoh penting di bumi Indonesia.
Komentar juga banyak yang berupa prediksi kapan akhirnya negeri 'Bhinneka Tunggal Ika' ini mampu menang terhadap corona.
Tak terkecuali Presiden Republik Indonesia Joko Widodo, beliau mengemukakan prediksinya mengenai kapan berakhirnya pandemi Covid-19 ini.
Simak ulasan khas Popmama.com berikut ini.
1. Prediksi Presiden Joko Widodo Corona usai akhir tahun 2020

Pada Kamis (16/4/2020) lalu, Presiden Republik Indonesia (RI) Joko Widodo dalam rapat terbatas melalui konferensi virtual mengatakan virus corona atau Covid-19 hilang dari Indonesia pada akhir tahun 2020.
Kemudian, ia juga mengatakan usai bencana Covid-19 ini sektor pariwisata akan mengalami kenaikan pada 2021.
"Saya meyakini ini hanya sampai akhir tahun, tahun depan akan terjadi booming di bidang pariwisata," katanya, pada rapat terbatas virtual di Istana Merdeka Jakarta.
Waduh akhir tahun lama sekali ya, Ma?
Bagi Mama yang mendengar ini mungkin sepertinya kabar yang kurang baik ini?
Tapi Ma, ini hanya prediksi jadi masih bisa salah sifatnya.
Kita yakini saja poin bahwasanya ekonomi pariwisata negara kita akan memuncak usai wabah jahat ini berakhir.
2. Badan Intelejen Negara (BIN) memperkirakan COVID-19 Memuncak pada Mei 2020

Pada Senin (13/3) lalu, Badan Intelejen Negara (BIN) memberikan prediksinya bahwasanya puncak Covid-19 di Indonesia akan terjadi sekitar 60 hingga 80 hari sejak pengumuman kasus positif pada 2 Maret silam.
Berdasarkan perhitungan tersebut, diperkirakan puncak ada pada tanggal 2 hingga 22 Mei 2020.
BIN baru memprediksi puncaknya saja lalu kapankah pucuk wabah ini? Kita doakan saja agar lebih cepat lebih baik ya Ma.
3. Ahli UGM prediksi Corona berakhir Mei 2020

Dengan didasari model probabilistik yang didasarkan pada data nyata, atau disebut dengan probabilistic data-driven model (PPDM).
Ahli statistika dan alumni Fakultas Matematika dan Ilmu Pengetahuan Alam Universitas Gadjah Mada (FMIPA UGM) memprediksi, pandemi virus corona akan berhenti pada Rabu, 29 Mei 2020 di Indonesia.
Dalam prediksinya tersebut disebutkan juga bahwa terdapat minimal 6.174 orang yang positif terinfeksi virus corona.
Lebih jauh ahli dari universitas ini juga menyebutkan bahwa pandemi corona akan selesai pada akhir Mei jika adanya kebijakan ketat pemerintah seperti partial lockdown, larangan ketat mudik, hingga ditiadakannya kegiatan seperti salat tarawih di masjid selama bulan suci Ramadan.
4. Guru besar Universitas Indonesia (UI) memprediksi Corona berakhir Mei 2020
Hasbullah Thabrany, Guru Besar Fakultas Kesehatan Masyarakat (FKM) UI, memprediksi pandemi corona di Indonesia akan berakhir pada Mei 2020.
Kemungkinan ini bisa saja apabila masyarakat bisa meningkatkan disiplin, seperti menjaga jarak dan tidak ada kontak tatap muka.
5. Alumni Departemen Matematika UI prediksi paling cepat awal Juni Corona usai

Tiga orang alumni Matematika UI juga membuat pemodelan menyebarnya Covid-19 di Indonesia.
Basisnya adalah penelitian yang dilakukan beberapa ilmuwan di Wuhan, Tiongkok.
Dalam penelitian itu disebutkan bahwa tanpa penanganan pemerintah, penyebaran Covid-19 baru akan usai akhir Agustus atau awal September dengan ratusan ribu kasus positif.
Puncaknya diramal akan berada pada tanggal 4 Juni yakni 11.318 kasus baru.
Sedangkan dengan adanya kebijakan berbasis ketegasan (strict intervention) dari pemerintah, virus corona di Indonesia paling cepat akan berakhir pada akhir Mei hingga awal Juni 2020.
Jumlah kasus positifnya diprediksi akan mencapai 17 ribu orang.
Para ahli boleh saja membuat penelitian dan berujung pada prediksi ya Ma. Kita harus tetap optimis dalam menghadapi pandemi ini ya, Ma.
Maka optimislah bahwa negeri agraris ini akan terbebas dari virus corona lebih cepat dari perkiraan.
Senada dengan yang dikatakan oleh Presiden RI mengenai optimisme bangsa dalam menghadapi Covid-19.
Ada baiknya kita persiapkan diri untuk menuju ke tempat wisata yang akan kita kunjung bersama keluarga usai wabah pandemi kita menangi bersama.
Ide yang bagus tentunya ya, Ma! Yuk kita pikirkan sembari tetap #dirumahaja.



















